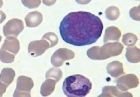
III型異型淋巴細胞

細胞簡介
 I型異型淋巴細胞
I型異型淋巴細胞 II型異型淋巴細胞
II型異型淋巴細胞人體血液中存在著幾種血液細胞。紅細胞和粒細胞等被稱之為終末細胞,意為它們的生命沒有回頭路,必須一直走下去,直至死亡。這樣的細胞除了行使各自的功能,不再進行任何形式的改變。
而淋巴細胞不是終末細胞,它還可以發生一些變化,比如原始細胞化和幼稚細胞化(俗稱“返祖現象”)。這樣的變化通常是由病毒或者藥物引起的應激反應,在顯微鏡下可以看到其細胞體積變大,細胞核體積也增大,細胞漿顏色加深,出現空泡等。這與正常淋巴細胞形態有明顯不同。這時候,就應報告發現異型淋巴細胞。人體異性淋巴細胞正常值為0-2.0%。
異型淋巴細胞(abnormallymphocyte)是一種形態變異的淋巴細胞,免疫表型顯示多屬T淋巴細胞。其形態變異是病毒或某些過敏原等因素刺激,T淋巴細胞反應性增生甚至發生母細胞化所致。正常人血片中偶可見到異型淋巴細胞。某些病毒感染,如EB病毒、巨細胞病毒、風疹病毒、肝炎病毒等均可見淋巴細胞增高,並出現數量不等的異型淋巴細胞。其中以EB病毒感染導致的傳染性單核細胞增多症表現尤為顯著,異型淋巴細胞10%,對其診斷具有一定價值。
分型
Ⅰ型
又稱空泡型或漿細胞型。胞體比正常淋巴細胞稍大,多為圓形、橢圓形、不規則形。細胞核為圓形、腎形、分葉狀,常偏位。染色質粗糙,呈粗網狀或小塊狀,排列不規則。胞質豐富、染深藍色、含空泡或呈泡沫狀。
Ⅱ型
又稱不規則型,或稱單核細胞型。胞體較大,外形常不規則,可有多個偽足。核形狀及結構與Ⅰ型相同,或更不規則,染色質較粗糙緻密。胞質豐富,染淡藍或灰藍色,有透明感,邊緣處著色深,一般無空泡,可有少數嗜天青顆粒。
Ⅲ型
又稱幼稚型或幼淋巴細胞型。胞體較大,細胞核圓形、卵圓形,染色質細緻呈網狀排列,可見1~2個核仁。胞質深藍色,可有少數空泡。
正常值
III型異型淋巴細胞
III型異型淋巴細胞顯微鏡目測法:<2%
異型淋巴細胞臨床意義:
臨床意義
增多
異型淋巴細胞數量增多可能是因為傳染性單核細胞增多症、流行性出血熱早期及病毒性肝炎、風疹、麻疹、腮腺炎、乙型腦炎、淋巴細胞白血病等病毒性感染。
異型淋巴細胞數量增多不一定就是淋巴細胞白血病。比如,有一種叫作“傳染性單核細胞增多症”的疾病,就可以出現血液中異型淋巴細胞增多,甚至達20%~30%。(參考值為<10%)。這種病為EB病毒感染,多數是經唾液感染,可以通過檢查血液中EB病毒的抗體來證實感染的存在。其他病毒的感染有時也會出現同樣的反應,有的藥物也會引發淋巴細胞的應激反應,所以出現幾個異型淋巴細胞時不必草木皆兵。但是,如果異型淋巴細胞數量持續增多,則不能大意,還應該再做一些其他的檢查,比如淋巴細胞免疫分型、細胞化學染色等,以排除淋巴細胞白血病。
臨床血液學檢測
| 血液一般檢測包括血液細胞成分的常規檢查、網織紅細胞檢測和紅細胞沉降率檢測。近年來由於血液學分析儀的廣泛套用,血液常規檢測的項目日益增多。本任務是關於臨床血液學檢測的相關詞條。 |

